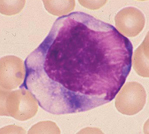

第4回 「マンスリー形態マガジン」 2011年6月号
前 略
いよいよ「形態マガジン号」は“形態の島”に向かって出航しました。
今回はリンパ球と単球の同定に挑戦しました。
第一回の観察は600倍に挑戦しましたが、個々の細胞には少々小さ過ぎる倍率でしたので、今回から通常の1000倍で挑戦します。私見の細胞観察シートを記入いただきましたが、今後は「細胞カルテ」と題し、細胞の同定に一役かうものになればと思っております。
また、みなさまから頂きましたご解答は今後集計してフイードバックしたいと考えております。
形態学スキスキグループのみなさまのご参加をお待ちしております!
草々
形態マガジン号キャプテン 阿南 建一 
問題
CASE 1~6の血液像の細胞同定を行ってください。
-
PB-MG.1000

-
PB-MG.1000

-
PB-MG.1000

-
PB-MG.1000
-
PB-MG.1000

-
PB-MG.1000

解答・解説
|
CASE 1 |
CASE 2 |
CASE 3 |
CASE 4 |
CASE 5 |
CASE 6 |
|---|---|---|---|---|---|---|
正解細胞 |
異常リンパ球 |
異常リンパ球 |
異型リンパ球 |
異型リンパ球 |
異常リンパ球 |
異常リンパ球 |
細胞の大きさ |
13μm以上 |
13μm以上 |
13μm以下 |
13μm以上 |
13μm以上 |
13μm以上 |
N-C比 |
低い |
低い |
低い |
低い |
高い |
高い |
核の偏在性 |
なし |
あり |
あり |
あり |
なし |
なし |
核形不整 |
なし |
軽度 |
軽度 |
軽度 |
切れ込み |
皺状 |
核小体 |
なし |
大きい・少ない |
なし |
なし |
なし |
なし |
核網 |
粗鋼 |
やや粗鋼 |
粗鋼 |
粗鋼 |
粗鋼 |
やや粗鋼 |
細胞質の色調 |
淡青色 |
深みの青色 |
全般に好塩基性 |
部分的に好塩基性 |
淡青色 |
淡青色 |
細胞質の顆粒 |
なし |
なし |
なし |
なし |
なし |
なし |
細胞質の封入体 |
なし |
なし |
なし |
なし |
なし |
なし |
細胞質の空胞 |
なし |
ある |
なし |
なし |
なし |
なし |
細胞質の辺縁 |
不規則性 |
不規則性 |
なし |
不規則性 |
規則性 |
不規則性 |
細胞質の突起 |
毛髪状 |
なし |
なし |
なし |
なし |
なし |
今回のねらい
今回も末梢血にみられる異型リンパ球と異常リンパ球の同定に挑戦しました。 リンパ球の同定を行う場合は、まず類似細胞として単球・異型リンパ球・異常リンパ球を両横に置き、異なる細胞所見をポイントにして相互の鑑別を行います。類似細胞は常に鑑別細胞になります。 細胞鑑別には前回にも触れましたが分析帰納法・比較類推法・除外法からみた論理的方法から同定へと進みます。 今回は異型リンパ球と異常リンパ球の鑑別になりますが、正常リンパ球は常に対照細胞として捉え、以下に特徴的な所見を述べます。 ・異型リンパ球 一般に大型(16μm以上)でN-C比は低く、核形不整はなし、あっても軽度。核小体は不明瞭で強度の好塩基性で多様性像が特徴です。 ・異常リンパ球 一般にN-C比は高く、核形不整は顕著。核小体は明瞭なことが多く、空胞・突起などを有することがあ り、単一像が特徴です。N-C比が高いとは核の占める割合が80%以上を目安とします。解説


この細胞は異常リンパ球に同定しました。
リンパ球とほぼ同大で、N-C比は低く、核形不整もなく、正常のリンパ球を思わせますが、同定ポイントは細胞質の毛髪状の突起です。この所見は正常のリンパ球や異常リンパ球にも認めることがありますが、それらの多くは水疱や蕾状であり、このような毛髪状は少ないようです。
本細胞は細胞質を異常所見として捉え、周囲の単一像を確認して異常リンパ球と同定します。
本例はヘアリー細胞白血病(B細胞)にみられたものです。


この細胞は異常リンパ球に同定しました。
大型で核網はやや粗鋼(繊細に近い)で明瞭な核小体(9時方向)を有し、深みのある好塩基性の細胞質には顕著な空胞を認めます。
これらの異常所見と周囲の単一像を確認して異常リンパ球として同定します。この空胞はズダンⅡ染色に陽性で中性脂肪といわれ特徴的な空胞を呈します。
本例はバーキットリンパ腫(B細胞)にみられたものです。


この細胞は異型リンパ球に同定しました。
大型(16μm以上)で、N-C比は低く、核網は粗鋼で、核小体は2個位ありそうですが輪郭が不明のため不明瞭としました。
細胞質の強好塩基性所見や周囲の多様性像(主に単球様、形質細胞様の混在)を確認し、異型リンパ球として同定します。
本例は伝染性単核球症にみられたものです。


この細胞は異型リンパ球に同定しました。
大型(16μm以上)で、N-C比は低く、核網は粗鋼で、細胞質には部分的な好塩基性がみられます。
周囲の多様性像(主に単球様、形質細胞様の混在)を確認して異型リンパ球として同定します。
本例は伝染性単核球症にみられたものです。


この細胞は異常リンパ球に同定しました。
リンパ球とほぼ同大ですが、異なる所見は独特な核形不整(核中心性への切れ込み)です。
N-C比も高いことや周囲の単一像を確認して異常リンパ球 に同定します。
本例はろ胞性リンパ腫(B細胞)にみられたものですが、特徴的な形態像ですので覚えておきましょう。


この細胞は異常リンパ球に同定しました。
N-C比は高く、核内への複雑な切れ込みが特徴的で、また核内では皴状にもみえます。それはテイッシュペーパーを丸めたようにもみえます。
本細胞はヘルパーT細胞の性格を有することで、ATL細胞と類似した形態を呈しますが、抗HTLV-Ⅰ抗体(-)、CD25(IL-2R)が陰性となりますので鑑別されます。本例はセザリー症候群にみられたものです。


この細胞は異常リンパ球に同定しました。
リンパ球とほぼ同大で、N-C比は低く、核形不整もなく、正常のリンパ球を思わせますが、同定ポイントは細胞質の毛髪状の突起です。この所見は正常のリンパ球や異常リンパ球にも認めることがありますが、それらの多くは水疱や蕾状であり、このような毛髪状は少ないようです。
本細胞は細胞質を異常所見として捉え、周囲の単一像を確認して異常リンパ球と同定します。
本例はヘアリー細胞白血病(B細胞)にみられたものです。


この細胞は異常リンパ球に同定しました。
大型で核網はやや粗鋼(繊細に近い)で明瞭な核小体(9時方向)を有し、深みのある好塩基性の細胞質には顕著な空胞を認めます。
これらの異常所見と周囲の単一像を確認して異常リンパ球として同定します。この空胞はズダンⅡ染色に陽性で中性脂肪といわれ特徴的な空胞を呈します。
本例はバーキットリンパ腫(B細胞)にみられたものです。


この細胞は異型リンパ球に同定しました。
大型(16μm以上)で、N-C比は低く、核網は粗鋼で、核小体は2個位ありそうですが輪郭が不明のため不明瞭としました。
細胞質の強好塩基性所見や周囲の多様性像(主に単球様、形質細胞様の混在)を確認し、異型リンパ球として同定します。
本例は伝染性単核球症にみられたものです。


この細胞は異型リンパ球に同定しました。
大型(16μm以上)で、N-C比は低く、核網は粗鋼で、細胞質には部分的な好塩基性がみられます。
周囲の多様性像(主に単球様、形質細胞様の混在)を確認して異型リンパ球として同定します。
本例は伝染性単核球症にみられたものです。


この細胞は異常リンパ球に同定しました。
リンパ球とほぼ同大ですが、異なる所見は独特な核形不整(核中心性への切れ込み)です。
N-C比も高いことや周囲の単一像を確認して異常リンパ球 に同定します。
本例はろ胞性リンパ腫(B細胞)にみられたものですが、特徴的な形態像ですので覚えておきましょう。


この細胞は異常リンパ球に同定しました。
N-C比は高く、核内への複雑な切れ込みが特徴的で、また核内では皴状にもみえます。それはテイッシュペーパーを丸めたようにもみえます。
本細胞はヘルパーT細胞の性格を有することで、ATL細胞と類似した形態を呈しますが、抗HTLV-Ⅰ抗体(-)、CD25(IL-2R)が陰性となりますので鑑別されます。本例はセザリー症候群にみられたものです。
これから先のページでは、医療関係者の方々を対象に医療機器・体外診断薬等の製品に関する情報を提供しております。当社製品を適正に使用していただくことを目的としており、一部の情報では専門的な用語を使用しております。
一般の方への情報提供を目的としたものではありませんので、ご了承ください。
医療関係者の方は、次のページへお進みください。
(お手数ですが、「進む」ボタンのクリックをお願いします)
